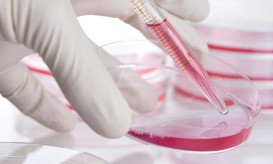

Ποια συμπτώματα προειδοποιούν ότι χρειαζόμαστε ένα check up, σύμφωνα με μία ειδικό
Η αδικαιολόγητη κούραση, οι διαταραχές στην ούρηση, ο πόνος στο στήθος και ο βήχας είναι μερικά από τα σημάδια...

Η αδικαιολόγητη κούραση, οι διαταραχές στην ούρηση, ο πόνος στο στήθος και ο βήχας είναι μερικά από τα σημάδια...

Αύριο Πέμπτη 30 Μαϊου ξεκινάνε οι Πανελλαδικές εξετάσεις 2024 για τα ΕΠΑΛ και μεθαύριο, Παρασκευή 31 Μαΐου για τα...

Η ΚΥΑ που απαλλάσσει από συμμετοχή σε φάρμακα και διαγνωστικές εξετάσεις τους πληγέντες από τις πλημμύρες του Σεπτεμβρίου στη...

Μετά από 42 ημέρες εγκλεισμού οι κάτοικοι της χώρας επιστρέφουν από σήμερα σε μια διαφορετική καθημερινότητα, προσαρμοσμένη στα νέα...

Αν είστε πάνω από 40 ετών, ακόμα κι αν αισθάνεστε καλά, θα πρέπει να επισκέπτεστε τακτικά τον γιατρό σας...

Αν είστε πάνω από 40 ετών, ακόμα κι αν αισθάνεστε καλά, θα πρέπει να επισκέπτεστε τακτικά τον γιατρό σας...

Η Παγκόσμια Ημέρα κατά του AIDS βρίσκει τους Έλληνες ασθενείς με σημαντικά προβλήματα προσβασιμότητας στις σύγχρονες διαγνωστικές εξετάσεις και...

Μπορούμε να κάνουμε το άγχος των εξετάσεων σύμμαχο μας; Σίγουρα αυτό ακούγεται ανέφικτο ή πάρα πολύ δύσκολο, κάθε φορά...

"Όταν οι συνταγές και τα παραπεμπτικά γεννιούνται μόνα τους" τιτλοφορεί ένα σχόλιο του σε blog ένας ιδιώτης γενικός γιατρός...

Η κ. Μαργαρίτα Μπουραντά, διοικήτρια των Νοσοκομείων Σύρου και Νάξου διαψεύδει κατηγορηματικά δημοσίευμα της εφημερίας Τα Νέα και παραθέτει...

Εξετάσεις προληπτικού ελέγχου σε ειδική, μειωμένη τιμή προσφέρει ο Όμιλος Ιατρικού Αθηνών, την περίοδο 01-08 Ιουνίου, με αφορμή την...

Στις 29 και 30 Απριλίου η ELPEN και η Μη Κερδοσκοπική Εταιρεία «Σύμπλευση» βρέθηκαν δίπλα στην κοινότητα της Ηρακλειάς...

Μέσα στον Ιανουάριο θα εκδοθεί η Υπουργική Απόφαση για τον καθορισμό κλειστών προϋπολογισμών και ορίων για όλες τις εξετάσεις...
Όπως αναφέρουν από τον ιατρικό Σύλλογο Πατρών "μετά την εφαρμογή της υπουργικής απόφασης (ΦΕΚ 2221 Β΄/18-7-2016) καθορισμού ορίων συνταγογράφησης...

Ο Ιατρικός Σύλλογος Λάρισας πήρε την σκυτάλη από δεκάδες φορείς στον χώρο της Υγείας που αντέδρασαν στην πρόχειρη και...